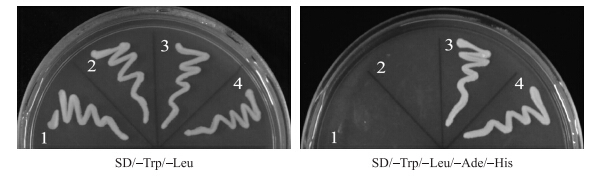

文章信息
- 钱瑜, 刘同坤, 侯喜林, 李英. 2015.
- QIAN Yu, LIU Tongkun, HOU Xilin, LI Ying. 2015.
- 不结球白菜Pol胞质雄性不育花酵母双杂交cDNA文库的构建及筛选
- Construction and screening of yeast two hybrid cDNA library of non-heading Chinese cabbage flowers with Pol CMS
- 南京农业大学学报, 38(1): 21-26
- Journal of Nanjing Agricultural University, 38(1): 21-26.
- http://dx.doi.org/10.7685/j.issn.1000-2030.2015.01.004
-
文章历史
- 收稿日期:2014-05-09
不结球白菜(Brassica campestris ssp.chinensis Makino)是十字花科芸薹属植物,属典型异花授粉作物,杂种优势明显,而利用雄性不育系是杂种优势利用的重要手段[1]。建立不结球白菜Pol胞质雄性不育花的全长cDNA文库对于利用酵母双杂交技术研究Pol胞质雄性不育中蛋白质与蛋白质的相互作用及不育相关基因的克隆和功能鉴定具有十分重要的意义,可以为系统认识BcRISP 1和orf224/atp6 等Pol胞质雄性不育相关基因[2]的信号肽识别蛋白和转运肽受体蛋白,探明其与Pol胞质雄性不育的关系奠定基础。
酵母双杂交(yeast two hybrid,Y2H)技术是利用激活报告基因的表达来研究真核生物中蛋白质的相互作用[3]。Y2H系统作为快速检测和鉴定蛋白质相互关系的标准方法之一[4],已经在拟南芥、水稻、李等作物中广泛应用[5, 6, 7]。SMART技术[8]是利用PowerScriptTMRT反转录酶兼有转移酶活性,使用极少量的mRNA或总RNA反转录得到大量双链DNA的技术。该方法实验操作简单,mRNA的降解低且文库的全长比例高。构建的cDNA文库的代表性和完整性均能达到分离筛选目的基因的要求[9]。
通过对不结球白菜Pol CMS的前期研究,我们利用抑制消减杂交获得1个表达序列标签,在胞质不育系中高度表达,确定为Rieske铁硫蛋白,命名为BcRISP1。RISP是电子传递链(ETC)上的泛醌-细胞色素C氧化还原酶催化亚基的一个成员,主要功能是传递电子、完成细胞色素C的还原。对不结球白菜BcRISP 1 基因的功能研究有助于进一步了解不结球白菜胞质雄性不育发生的机制。本文利用SMART技术和酵母双杂交技术,以Pol胞质雄性不育花mRNA为模板,构建不结球白菜Pol胞质雄性不育花酵母双杂交cDNA文库。通过对文库转化率、滴度、重组率的检测,确定所建的文库达到分离筛选目的基因和克隆等后续研究的标准。再利用酵母双杂交技术,从cDNA文库中筛选出与BcRISP1互作的蛋白,从互作的角度为研究BcRISP 1 在不结球白菜胞质雄性不育系中的功能提供更多依据。
1 材料与方法 1.1 材料 1.1.1 试验材料
植物材料为不结球白菜Pol胞质雄性不育系‘矮脚黄’的花,由南京农业大学白菜课题组提供。于2009年10月底播种于南京农业大学江浦农场,于次年开花期取不结球白菜Pol胞质雄性不育系的花作为供试材料。 1.1.2 试剂
大肠杆菌菌株DH5α为本实验室保存;酵母菌株Y187、AH109,载体pMD18-T、pGBK T-7、pGADT7-Rec和pDONR221,BiFC-YN、BiFC-YC,Make Your Own“Mate & PlateTM”Library System User Manual Yeastmaker Yeast Transformation System 2购自Clontech公司;E.Z.N.A. Mag-Bind mRNA Kit购自OMEGA公司;酵母质粒提取试剂盒购自Tiangen(北京)公司。 1.2 试验方法 1.2.1 总RNA的提取与纯化
取不结球白菜Pol胞质雄性不育系的花在液氮下快速研磨成粉状,总RNA的提取按照总RNA提取试剂盒说明书进行。 1.2.2 mRNA的分离与纯化
mRNA的分离与纯化按照E.Z.N.A. Mag-Bind mRNA Kit说明书进行。 1.2.3 双链cDNA的合成
双链合成的具体步骤参照崔红军等[10]的文库构建方法,对PCR获得的双链cDNA进行纯化,最后利用1 g · L-1琼脂糖凝胶电泳检测双链纯化的结果。 1.2.4 cDNA文库的建立
制备转化用酵母Y187感受态细胞。将酵母菌株Y187接种于YPDA液体培养基中复性,30 ℃振荡孵育8 h左右。取5 μL新鲜菌液于50 mL YPDA液体培养基中扩繁,30 ℃振荡孵育16~20 h至D600达到0.15~0.3,700 g离心5 min,弃上清液。加入100 mL YPDA液体培养基重悬浮,30 ℃静置孵育3 h至D600达到0.4~0.5,700 g离心5 min,弃上清液。加入60 mL灭菌的ddH2O,700 g离心5 min,弃上清液。加入3 mL 1.1×TE/LiAc溶液重悬浮,分装在灭菌的1.5 mL离心管中,14 000 r · min-1离心15 s,弃上清液。加入600 μL 1.1×TE/LiAc溶液重悬浮,即为酵母Y187感受态细胞。cDNA文库构建的具体步骤参照崔红军等[10]的文库构建方法,最后获得NaCl溶液(0.9%)悬浮细胞。 1.2.5 cDNA文库的检测与鉴定
转化后的反应液分别稀释10、100、1 000和10 000倍,按每个SD/-Leu固定培养基平板(直径为150 mm)150 μL涂布均匀,30 ℃孵化2~3 d,统计不同稀释倍数下平板上的菌落数量,计算转化效率。计算公式为:平均转化率(每μg pGADT7-Rec的转化子数)=平板上的单克隆数×稀释倍数×150。用冷冻的含有25%甘油的YPD培养基重悬浮SD/-Leu固体培养基上的阳性克隆,采用相同的方法稀释菌液,用血球计数板统计细胞浓度。滴度的计算公式为:滴度=平板上的单克隆数×稀释倍数×10。挑取50个菌落为模板,根据两步法扩增PCR,统计扩增出外源重组片段的菌落数,计算文库重组率。文库重组率=(有外源片段的反应个数/反应总数)×100%。 1.2.6 重组诱饵质粒载体pGBK T-7-BcRISP1的构建
根据BcRISP 1 cDNA序列设计含有EcoRⅠ和BamHⅠ酶切位点的特异引物,上游引物BcRISP1-F:5′-CAGAATTCATGCTGCGAATTGCAGGG-3′,下游引物BcRISP1-R:5′-TTGGATCCTCAACCAATGAGTAACTT-3′。以不结球白菜Pol胞质雄性不育花cDNA为模板,扩增BcRISP1诱饵片段。扩增产物连接pMD18-T载体,转化大肠杆菌,提取阳性克隆的质粒。双酶切重组质粒pMD18-BcRISP1和空载体pGBK T-7质粒。37 ℃酶切反应,回收酶切产物,T4连接酶16 ℃连接6 h,连接产物重组质粒pGBK-BcRISP1转化大肠杆菌。筛选阳性克隆并送金斯瑞公司测序。 1.2.7 诱饵载体转化酵母菌株自激活检测
将空载体pGBK T-7质粒(作为对照)和重组质粒pGBK-BcRISP1分别转入AH109酵母感受态细胞,并分别涂布于SD/-Trp和SD/-Trp/-Leu/-Ade/-His固体培养基上,30 ℃孵育2~3 d,观察菌落形态及其颜色,以此判断是否具有自激活性。 1.2.8 诱饵载体小规模转化酵母细胞
从SD/-Trp固体培养基上选取新鲜的菌落,于SD/-Trp液体培养基,30 ℃过夜培养,至D600超过0.8。离心,弃上清液,用SD/-Trp液体培养基3 mL重悬浮。加入1 mL不育花cDNA文库,混匀于45 mL 2×YPDA液体培养基中,于2 L的锥形瓶30 ℃、50 r · min-1孵育20 h左右。离心,弃上清液,用0.5×YPDA液体培养基重悬浮。涂布于SD/-Trp/-Leu/-Ade/-His营养缺陷固体培养基上,30 ℃孵育2~3 d。 1.2.9 酵母质粒提取及测序
酵母质粒提取按照酵母质粒提取试剂盒的说明方法进行。获得的酵母质粒转化大肠杆菌DH5α,筛选阳性克隆提取质粒。根据pGAD T7-Rec载体设计通用引物,上游引物3AD:5′-AGATGGTGCACGATGCACAG-3′,下游引物T7:5′-TAATACGACTCACTATAGGG-3′,对质粒进行PCR扩增,质粒送金斯瑞公司测序。 1.2.10 酵母共转化验证
提取的含有互作基因的酵母质粒与pGAD(作为对照)分别同重组质粒pGBK-BcRISP1共转化AH109酵母感受态细胞。按照1 ∶ 10、1 ∶ 100、1 ∶ 1 000比例分别涂布于SD/-Trp/-Leu和SD/-Trp/-Leu/-Ade/-His固体培养基,30 ℃培养。 2 结果与分析
2.1 总RNA的提取和mRNA的分离纯化
利用UV 800仪分别测定总RNA及mRNA的D260、D280、D260/D280和浓度。总RNA样品中D260/D280=2.01,质量浓度为0.431 μg · μL-1,mRNA样品中D260/D280=1.98,质量浓度为0.175 μg · μL-1,说明获得的总RNA和mRNA没有DNA、蛋白质和其他小分子的污染,可以进行下一步试验。
12 g · L-1琼脂糖凝胶电泳检测结果(图 1-A)显示:总RNA有18 S和28 S两条带,证明抽提的RNA样品质量完好,没有发生降解。而mRNA有一条弥散的带(图 1-B),说明mRNA分离纯化效果是理想的。
 | 图 1 不结球白菜Pol胞质雄性不育系花总RNA(A)和mRNA(B)电泳图 Fig. 1 Electrophoresis of total RNA(A)and mRNA(B)of Pol CMS flowers in non-heading Chinese cabbage M:DL2000 marker;1:总RNA Total RNA;2:mRNA |
以纯化的mRNA为模板进行反转录合成第1链,再扩增合成双链cDNA,合成的双链cDNA电泳呈弥散状,大小分布在100~4 000 bp范围内。用CHROMA SPINTM TE-400 Column纯化双链cDNA,去除杂质和小片段cDNA,500 bp以下的片段基本被去除(图 2),与预期结果一致。
 | 图 2 双链cDNA电泳图 Fig. 2 Electrophoresis of double- strand cDNAM:DL2000 marker;1:双链cDNA Double-strand cDNA |
试验得到文库的平均转化率为每μg pGADT7-Rec 1.80×106转化子,所得文库的平均滴度为1.21×107 CFU · mL-1,重组率为94%。
2.4 酵母双杂交诱饵载体的构建
目的片段连接pMD18-T载体,EcoRⅠ和BamHⅠ双酶切pMD18-BcRISP1重组质粒和空载体pGBK T-7质粒,获得与PCR产物大小一致的酶切产物(图 3-A)。T4连接酶连接,获得插入pGBK T-7载体的诱饵载体pGBK T-7-BcRISP1,双酶切重组质粒获得与预期片段大小一致的条带(图 3-B)。
 | 图 3 BcRISP1扩增片段(A)和重组质粒(B)双酶切电泳图 Fig. 3 Electrophoresis of BcRISP1 amplified fragments(A) and recombinant plasmid(B)after digestionM:DL2000 marker;M′:DL9000 marker A |
用诱饵载体与空载体(作为对照)分别转化酵母AH109菌株,转化菌落可以在SD/-Trp上生长获得白色菌落,且诱饵载体和对照相比生长速度没有明显差距。说明诱饵载体没有毒性,且具有自激活性,可用于下一步筛选试验。诱饵载体筛选酵母文库进行酵母双杂交试验,从SD/-Trp/-Leu/-Ade/-His固体培养基上筛选出BcRISP 1 基因的互作蛋白,检测到9个互作菌落。提取互作菌落的酵母质粒,转化大肠杆菌,电泳检测条带(图 4),菌液测序。序列通过NCBI数据库的BLAST比对发现,只有2个真正互作的蛋白具有进一步研究的意义。其中3个克隆为1个细胞色素基因CYP 81 G(cytochrome P450 family 81,CYP81G)和2个质膜内在蛋白基因PIP 2 (plasma membrane intrinsic protein subfamily,PIP2),其余几个片段太小,比对结果精确度不高。
 | 图 4 阳性克隆PCR鉴定电泳图 Fig. 4 Electrophoresis of positive clones M:DL2000 marker;1~9:互作蛋白PCR条带 PCR lines of interaction proteins |
选取互作蛋白CYP81G和PIP2的菌落分别在SD/-Trp/-Leu和SD/-Trp/-Leu/-Ade/-His固体培养 基上划板生长。如图 5所示:筛选出来的互作蛋白CYP81G和PIP2的菌株在SD/-Trp/-Leu和SD/-Trp/- Leu/-Ade/-His缺陷型固体培养基上都能生长,而对照空载体pGAD+pGBK和pGAD+pGBK-BcRISP1共转化酵母只能在SD/-Trp/-Leu培养基上生长。
| 图 5 BcRISP1互作蛋白筛选 Fig. 5 Screening for interaction proteins of BcRISP1 1:pGAD+pGBK;2:pGAD+pGBK-BcRISP1;3:pGAD-CYP81G+pGBK-BcRISP1;4:pGAD-PIP2+pGBK-BcRISP1 |
诱饵载体pGBK-BcRISP1分别与含有CYP81G和PIP2互作基因的质粒共转化酵母菌株AH109,然后在不同浓度梯度的SD/-Trp/-Leu/-Ade/-His缺陷型固体培养基上培养,结果(图 6)发现各组酵母细胞均能生长。
 | 图 6 BcRISP1与互作蛋白共转化验证 Fig. 6 Contransformation analysis of interaction between BcRISP1 and the interaction proteins |
关于植物Pol胞质雄性不育的研究较多[11, 12, 13, 14],但关于Pol胞质雄性不育基因之间的互作以及导致胞质雄性不育的信号传递通路研究,国内外报道较少。自从酵母双杂交技术1989年第一次被报道以来,在生物体中被广泛应用于确定蛋白与蛋白的互作关系[15, 16],它是一种能直接检测胞内蛋白质相互作用非常有效的分子生物学方法[17],为寻找兴趣蛋白和为已知互作蛋白特征描述提供了一个方便的方法。
酵母双杂交技术可以用来研究高等植物基因组编码的蛋白质之间的互作,从而来探究与已知基因在生物学功能上的联系。訾亮等[18]通过酵母双杂交筛选获得若干个与拟南芥NiNJA基因互作的蛋白,为鉴定茉莉酸的信号调控途径打下基础。PIP2作为质膜内在蛋白家族的一员,在酵母细胞中表达会调控过氧化氢在细胞中的生成。雄性不育植株活性氧积累过多,会导致代谢失调造成花蕾败育。陈晓峰等[19]研究发现:在甜椒花蕾败育过程中,过氧化氢在小蕾期至中蕾期保持较高的水平,从而导致不育系MDA含量过高,造成花蕾败育。PIP2还是离子通道中普遍存在的调制器,同Ca2+和电压一起成为第3个调控BK通道活性的关键成员[20]。BK-钙通道复合体的形成对信号转导具有重要的生理学意义,BK通道还与细胞骨架蛋白、蛋白激酶等多种其他分子存在着功能性的耦合[21]。PIP2不仅与植物雄性不育有着密切的联系,而且还同信号转导息息相关。植物细胞色素P450具有广泛的催化活性,主要分布在内质网和线粒体内膜上,其功能主要是参与生物合成途径和参与生物解毒途径,细胞色素P450作为一种末端加氧酶参与了生物体内的甾醇类激素合成等过程[22]。另外,参与次生代谢的P450在分子和酶水平上的多样性决定了其功能的多样性,如肉桂酸4-羟化酶除参与催化生物合成反应外,还在植物的生长和发育中发挥重要作用[23]。细胞色素P450的生物合成也从一定程度上解释了其对植物雄性不育产生的影响。本试验利用酵母双杂交,从构建的文库中筛选出与BcRISP1互作的蛋白CYP81G和PIP2。质粒共转化试验证明pGBK-BcRISP1与CYP81G、PIP2酵母共转化产物均能在SD/-Trp/-Leu/-Ade/-His缺陷型固体培养基上生长,确认了其互作关系。从不同的角度对互作蛋白PIP2和植物细胞色素P450成员CYP81G在生物学功能方面的讨论阐述了其与雄性不育的相关性,为更好地解释目的基因BcRISP 1 与雄性不育的关系提供了更充分的理论依据。而文库的建立和互作蛋白的筛选为不结球白菜Pol胞质雄性不育相关基因的克隆和功能研究提供了很好的前提条件,也为雄性不育发生过程中相关基因之间的互作、信号转导及调控等的机制研究奠定了基础。
| [1] | 邓晓辉,张蜀宁,侯喜林,等. 胞质雄性不育相关基因的克隆及其表达分析[J]. 西北植物学报,2006,26(9):1859-1863 [Deng X H,Zhang S N,Hou X L,et al. Cloning and expression of genes related with cytoplasmic male sterility[J]. Acta Bot Boreal-Occident Sin,2006,26(9):1859-1863(in Chinese with English abstract)] |
| [2] | 袁美,杨光圣,傅廷栋,等. 甘蓝型油菜Pol CMS育性恢复基因对orf224/atp6的转录调控[J]. 遗传学报,2003,30(5):469-473 [Yuan M,Yang G S,Fu T D,et al. Transcriptional control of orf224/atp6 by the pol CMS restorer Rfp gene in Brassica napus L.[J]. Acta Genetica Sinica,2003,30(5):469-473(in Chinese with English abstract)] |
| [3] | Fields S,Song O. A novel genetic system to detect protein-protein interactions[J]. Nature,1989,340(6230):245-246 |
| [4] | Fukao Y. Protein-protein interactions in plants[J]. Plant Cell Physiology,2012,53(4):617-625 |
| [5] | Costa M,Nobre M S,Becker J D,et al. Expression-based and co-localization detection of arabinogalactan protein 6 and arabinogalactan protein 11 interactors in Arabidopsis pollen and pollen tubes[J]. BMC Plant Biology,2013,13(7):1871-1890 |
| [6] | Singh R,Lee M O,Lee J E,et al. Rice mitogen-activated protein kinase interactome analysis using the yeast two-hybrid system[J]. Plant Physiology,2012,160(1):477-487 |
| [7] | Matsumoto D,Yamane H,Abe K,et al. Identification of a Skp1-like protein interacting with SFB,the pollen S determinant of the gametophytic self-incompatibility in Prunus[J]. Plant physiology,2012,159(3):1252-1262 |
| [8] | Zhu Y Y,Maehleder E M,Chenchik A,et al. Reverse transcriptase template switching:a SMART approach for full-length cDNA library construction[J]. Biotechniques,2001,30(4):892-897 |
| [9] | 何晓兰,许玲,徐照龙,等. 大豆高盐胁迫下根部组织酵母双杂交文库的构建与分析[J]. 上海农业学报,2013,29(6):20-23 [He X L,Xu L,Xu Z L,et al. Construction and analysis of a yeast two-hybrid cDNA library of soybean root tissue under high salt stress[J]. Acta Agriculturae Shanghai,2013,29(6):20-23(in Chinese with English abstract)] |
| [10] | 崔红军,张军杰,黄玉碧. 玉米根部酵母双杂交cDNA文库的构建及评价[J]. 分子植物育种,2008,6(1):161-164 [Cui H J,Zhang J J,Huang Y B. Construction and evaluation of yeast two hybrid cDNA library of maize root[J]. Molecular Plant Breeding,2008,6(1):161-164(in Chinese with English abstract)] |
| [11] | Hommey L,Brown G G. Organization differences between cytoplasmic male sterile and fertile Brassica mitochondrial genomes are confined to a single transposed locus[J]. Nuclelc Acids Resl,1993,21(8):1903-1909 |
| [12] | Hanson M R,Bentolila S. Interactions of mitochondrial and nuclear genes that affect male gametophyte development[J]. Plant Cell,2004,16:154-169 |
| [13] | 张占芳,李睿,仲天庭,等. 水稻细胞质雄性不育系和保持系对外源茉莉酸响应以及内源茉莉酸合成的差异[J]. 南京农业大学学报,2014,37(6):7-12. doi:10.7685/j.issn.1000-2030.2014.06.002 [Zhang Z F,Li R,Zhong T T,et al. Differences of jasmonic acid sensitivity and endogenous jasmonic acid synthesis between cytoplasmic male sterile line and its maintainer line in rice[J]. Journal of Nanjing Agricultural University,2014,37(6):7-12(in Chinese with English abstract)] |
| [14] | 蔡健,范海燕,廖秋平,等. 水稻恢复基因Rf3和Rf4聚合效应分析[J]. 南京农业大学学报,2014,37(3):20-26. doi:10.7685/j.issn.1000-2030.2014.03.003 [Cai J,Fan H Y,Liao Q P,et al. Analysis of pyramiding effect of the Rf3 and Rf4 genes on fertility restoration in rice with cytoplasmic male sterility[J]. Journal of Nanjing Agricultural University,2014,37(3):20-26(in Chinese with English abstract)] |
| [15] | Chen J,Carter M B,Edwards B S,et al. High throughput flow cytometry based yeast two-hybrid array approach for large-scale analysis of protein-protein interactions[J]. Cytometry A,2012,81(1):90-98 |
| [16] | 楼望淮,蒋甲福,陈素梅,等. 菊花B病毒外壳蛋白互作蛋白的筛选[J]. 南京农业大学学报,2013,36(4):43-48. doi:10.7685/j.issn.1000-2030.2013.04.008 [Lou W H,Jiang J F,Chen S M,et al. Screening of proteins interacting with the coat protein of Chrysanthemum virus B[J]. Journal of Nanjing Agricultural University,2013,36(4):43-48(in Chinese with English abstract)] |
| [17] | 郑立双,李向楠,孙城涛,等. 酵母双杂交技术及应用的研究进展[J]. 中国畜牧兽医,2013,40(9):105-108 [Zheng L S,Li X N,Sun C T,et al. Research progress on yeast two-hybrid technology and application[J]. China Animal Husbandry and Veterinary Medicine,2013,40(9):105-108(in Chinese with English abstract)] |
| [18] | 訾亮,洪灏,翟金玲,等. 拟南芥NiNJA基因酵母双杂诱饵载体构建及互作蛋白的筛选[J]. 热带生物学报,2013,4(1):31-35 [Zi L,Hong H,Zhai J L,et al. Construction of bait vector for NiNJA gene in Arabidopsis and screening the interacted proteins using yeast two-hybrid[J]. Journal of Tropical Biology,2013,4(1):31-35(in Chinese with English abstract)] |
| [19] | 陈晓峰,侯喜林,刘金兵,等. 甜椒细胞质雄性不育新种质花蕾败育与活性氧代谢关系研究[J]. 南京农业大学学报,2007,30(4):26-29. doi:10.7685/j.issn.1000-2030.2007.04.006 [Chen X F,Hou X L,Liu J B,et al. Relationship between new cytoplasmic male sterility and reactive oxygen species metabolism in sweet pepper buds[J]. Journal of Nanjing Agricultural University,2007,30(4):26-29(in Chinese with English abstract)] |
| [20] | Tang Q Y,Zhang Z,Meng X Y,et al. Structural determinants of PIP2 regulation of BK channel activity through the RCK1 Ca2+ coordination site[J]. J Biol Chem,2014,289:18860-18872 |
| [21] | 刘永锋,孔文娟,王伟. BK通道功能性复合体的研究进展[J]. 现代生物医学进展,2014,14(9):1759-1762 [Liu Y F,Kong W J,Wang W. Functional complexes of BK channels[J]. Progress in Modern Biomedicine,2014,14(9):1759-1762(in Chinese with English abstract)] |
| [22] | Simon T,Steg P G,Gilard M,et al. Clinical events as a function of proton pump inhibitor use,clopidogrel use,and Cytochrome P450 2C19 genotype in a large nationwide cohort of acute myocardial infarction[J]. Am Heart Assoc,2011,123(5):474-482 |
| [23] | Ehlting J,Hamberger B,Million-Rousseau R,et al. Cytochromes P450 in phenolic metabolism[J]. Phytochem Rev,2006,5(23):239-270 |




